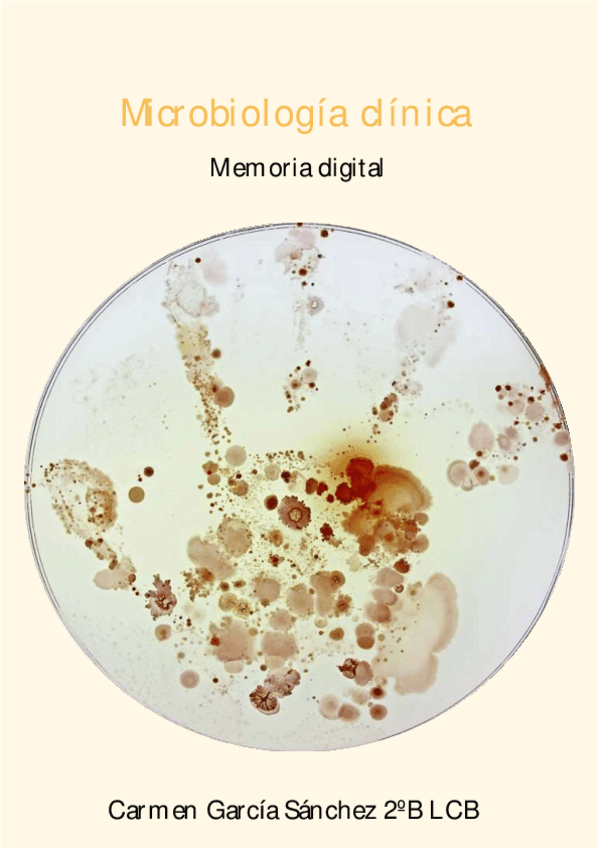
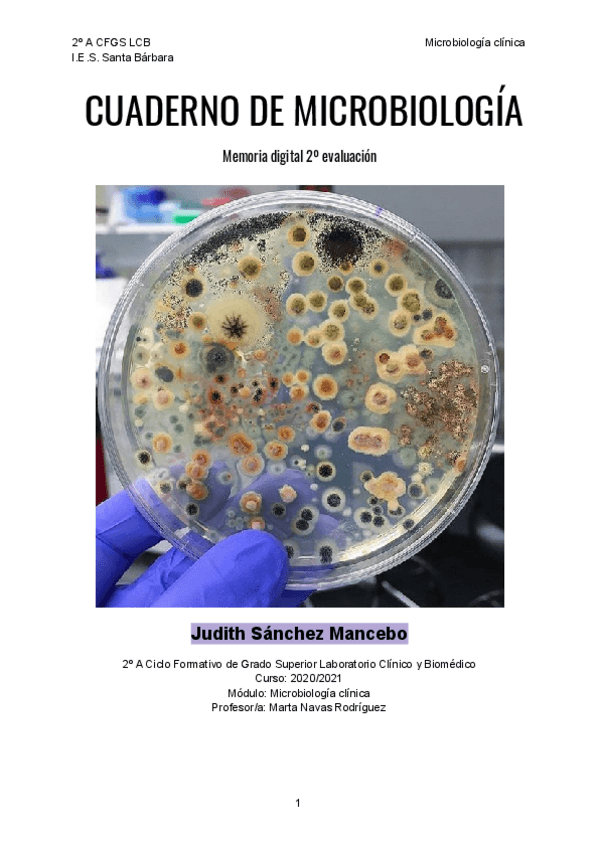
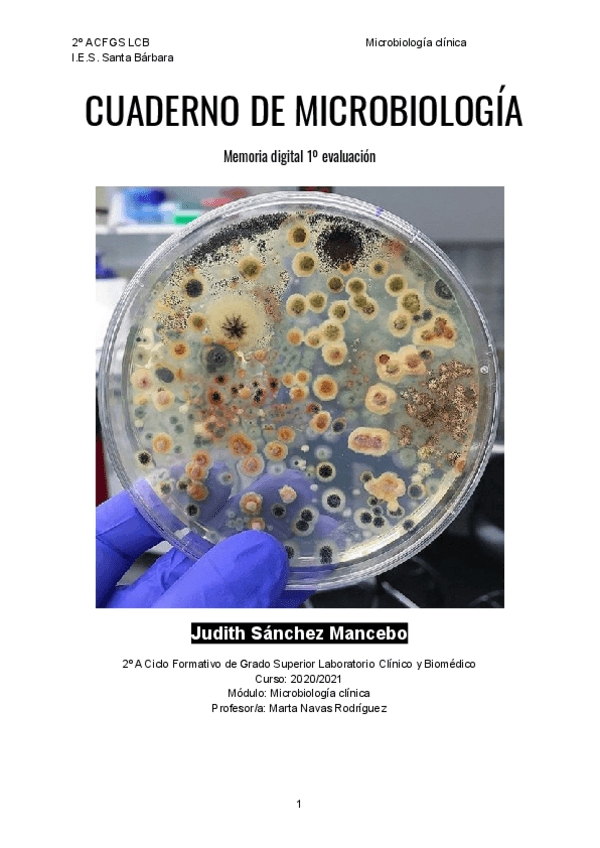
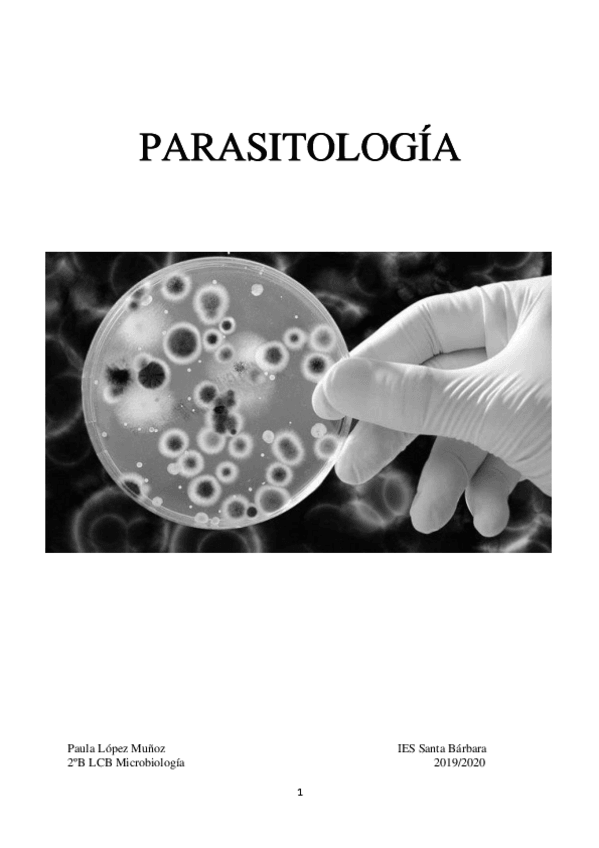

Microbiología clínica
apuntes
-
LIBROS
He publicado nuevos apuntes de Microbiología clínica: LIBROS
He publicado nuevos practicas de Microbiología clínica: seimc-procedimientomicrobiologia35.pdf
He publicado nuevos practicas de Microbiología clínica: CUADERNO-DE-PRACTICAS-Microbiologia-Clinica.pdf
He publicado nuevos practicas de Microbiología clínica: CUADERNO-DE-PRACTICAS-DE-MICROBIOLOGIA.pdf
He publicado nuevos ejercicios de Microbiología clínica: UD-1-Microbiologia.pdf
He publicado nuevos ejercicios de Microbiología clínica: 1º Trimestre Microbiología.pdf
He publicado nuevos apuntes de Microbiología clínica: Temario-micro-primer-trimestre.pdf
apuntes
-
Cuaderno de Practica
He publicado nuevos apuntes de Microbiología clínica: Cuaderno de Practica
He publicado nuevos trabajos de Microbiología clínica: Cuaderno-microbiologia-clinica-completo.pdf
He publicado nuevos apuntes de Microbiología clínica: Actividades-microbiologia-Carmen.pdf
apuntes
-
UD 6 y 7
He publicado nuevos apuntes de Microbiología clínica: UD 6 y 7
apuntes
-
Microbiología clínica
He publicado nuevos apuntes de Microbiología clínica: Microbiología clínica
He publicado nuevos practicas de Microbiología clínica: Cuaderno-Micro-2o-Ev.pdf
practicas
-
Prácticas Micro
He publicado nuevos practicas de Microbiología clínica: Prácticas Micro
He publicado nuevos examenes de Microbiología clínica: Cuaderno-Micro-2o-Ev.pdf
He publicado nuevos practicas de Microbiología clínica: 1er-trimestre-Micro.pdf
He publicado nuevos apuntes de Microbiología clínica: Memoria-Digital-Microbiologia-2.pdf
He publicado nuevos apuntes de Microbiología clínica: Memoria-Digital-Microbiologia.pdf
He publicado nuevos apuntes de Microbiología clínica: Tabla-Cocos-Gram--y-.pdf
He publicado nuevos practicas de Microbiología clínica: Practicas-micro.pdf
He publicado nuevos practicas de Microbiología clínica: PARASITOLOGIA.pdf
apuntes
-
Microbiología Clínica
He publicado nuevos apuntes de Microbiología clínica: Microbiología Clínica
apuntes
-
VIROLOGÍA
He publicado nuevos apuntes de Microbiología clínica: VIROLOGÍA
apuntes
-
Parasitología
He publicado nuevos apuntes de Microbiología clínica: Parasitología
ejercicios
-
Preguntas posibles
He publicado nuevos ejercicios de Microbiología clínica: Preguntas posibles
apuntes
-
Trabajo parasitología
He publicado nuevos apuntes de Microbiología clínica: Trabajo parasitología
He publicado nuevos apuntes de Microbiología clínica: 16.-PARASITOLOGIA-generalidades.doc
apuntes
-
Microbiología
He publicado nuevos apuntes de Microbiología clínica: Microbiología
He publicado nuevos apuntes de Microbiología clínica: tabla-bacteriana.jpg
He publicado nuevos apuntes de Microbiología clínica: 06.-NUTRICION-Y-METABOLISMO-BACTERIANO.pdf
He publicado nuevos apuntes de Microbiología clínica: 07.-MEDIOS-DE-CULTIVO.pdf
He publicado nuevos apuntes de Microbiología clínica: 09.-BACILOS-Y-COCOS-GRAM-NEGATIVOS.doc

¡Estás al día!
Has visto todos los archivos